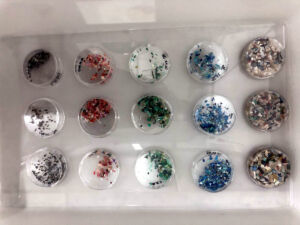

Cuando en 1972 los investigadores E. J. Carpenter y K. L. Smith alertaron en un artículo de la revista Science de la presencia de partículas de plástico de pequeño tamaño en medio del Atlántico Norte (en el Mar de los Sargazos, concretamente), la comunidad científica no se mostró especialmente alarmada a pesar de lo insólito que resultaba encontrar estos diminutos fragmentos en un punto oceánico tan alejado de cualquier población. En aquella época, estos investigadores ni siquiera emplearon la palabra “microplásticos”, pero ya estaban dando la señal de alarma sobre un problema que, en la actualidad, por fin está recibiendo más atención mediática y, sobre todo, científica.
Fue en 2004 cuando Richard Thompson, de la Universidad de Plymouth, reavivó este problema y logró generar más interés social hacia él gracias a un artículo, de nuevo en Science, titulado de manera contundente “Perdido en el mar. ¿Dónde está todo el plástico?”, en el que volvía a señalar la presencia cada vez mayor de partículas de plástico muy pequeñas en el mar y, además, las denomina microplásticos por primera vez. A raíz de ese trabajo quedó establecido que se trata de partículas con un tamaño inferior a 5 milímetros; donde hay todavía debate es en fijar su límite, que algunos autores cifran en una micra y otros llegan hasta los cien nanómetros.
En ese momento la comunidad científica finalmente despertó y desde entonces se ha producido un crecimiento exponencial de artículos sobre el asunto, hasta llegar a un punto en que, solo en 2019, hubo en torno a 800 trabajos centrados en este problema, hay volúmenes de revistas completos prácticamente dedicados al tema e, incluso, existe un congreso internacional llamado Micro, que desde 2016 se celebra cada dos años en Lanzarote, auspiciado por la Reserva de la Biosfera de la isla, al cual acuden los especialistas más reconocidos y en 2020, por razones de sobras conocidas, se celebrará íntegramente de manera telemática.
Un ejemplo de esa preocupación creciente lo tenemos en la Universidad de La Laguna donde el grupo de investigación en Química Analítica Aplicada lleva prácticamente desde su fundación en febrero de 2018 trabajando en varios proyectos científicos, artículos y acciones de divulgación centradas específicamente en este problema. Su director, Javier Hernández Borges, explica que su grupo nació con el propósito de desarrollar metodologías de análisis con mucha aplicabilidad, para que “la química no se quede en el laboratorio y vaya más allá para aportar beneficio a la sociedad. Obviamente, las líneas de investigación van caminando, uno puede tener unas ideas y luego descubre que tiene medios y personal para abordar otras”.
Y más o menos eso es lo que ocurrió con los microplásticos: el grupo comenzó a trabajar en un proyecto de la Fundación CajaCanarias sobre el impacto de los plásticos en las playas de Tenerife, concretamente sobre la presencia de ftalatos, que son compuestos que se añaden a los plásticos para facilitar su moldeado y que pueden migrar fácilmente a su entorno. Como el proyecto analizaba esos residuos, también incorporaba tangencialmente los microplásticos. “Fue ese proyecto el que nos hizo darnos cuenta de que ahí había una línea de investigación importante, que en Canarias apenas se habían realizado estudios de estas características y, por eso, abrimos esta línea sobre microplásticos”.
Un problema por mensurar
La proliferación de microplásticos origina varios problemas actualmente en estudio, cuyas consecuencias, en algunos casos, todavía no se han podido establecer con exactitud. Básicamente, habría dos grandes situaciones que han alertado a la comunidad científica: la primera, que estas partículas ya no están solamente en el medio acuático, sino que ya han llegado al aéreo y al terrestre, por lo cual ya se pude hablar de un “ciclo del plástico” similar al de otras sustancias en el medio ambiente. En este sentido, el investigador señala que ya hay estudios que detallan su presencia en los grandes parques nacionales de Estados Unidos o, incluso, en el Círculo Polar Ártico y en la Antártida, todas ellas localizaciones alejadas de núcleos poblacionales, lo cual indica que ese plástico ha sido trasportado desde miles de kilómetros.
La segunda señal de alarma es que los microplásticos ya han llegado a la cadena trófica, de tal manera que al ser consumidos por organismos que, a su vez, forman parte de la dieta de otros, su propagación ya ha llegado hasta los estómagos humanos. Hernández Borges lo expone con un ejemplo ciertamente inquietante: “algunos estudios indican que el ser humano ingiere el equivalente a una tarjeta de crédito de plástico a la semana”.
Sobre su presencia en todos los compartimentos ambientales, el experto explica que los microplásticos en el suelo pueden llegar, además de por las partículas que caigan del aire, por materiales de cultivo (como los invernaderos o los acolchados plásticos) o incluso por el tráfico rodado, dado que las ruedas están hechas de caucho natural pero también de plásticos sintéticos que, al desgastarse, aparece en estas pequeñas partículas. Al medio acuático llegan cantidades importantes por los núcleos poblacionales cercanos y, también, a través de los ríos y barrancos.
Es al llegar al medio marino cuando el plástico de mayor tamaño acaba fragmentado por la acción de la luz, el oxígeno atmosférico, las altas temperaturas y la degradación mecánica (choques y golpes), produciendo los llamados microplásticos secundarios. Los primarios serían aquellos que ya son sintetizados directamente con esos pequeños tamaños, como los pellets o granzas, (pequeñas esferas de plástico duro que se venden a la industria para su fundición y creación de envases y objetos de mayor tamaño), las microesferas que se utilizan en cremas exfoliantes y pastas de dientes e, incluso, la purpurina. “Los países son cada vez más conscientes de los problemas que plantean los microplásticos primarios, por lo que muchos están legislando para prohibirlos”.
Sobre su entrada en la cadena trófica, Hernández Borges explica que los fragmentos más diminutos son asimilados por organismos filtradores como los mejillones, y también están presentes en el zooplancton y, por tanto, finalizan en peces que, a su vez, también acaban con microplásticos en su interior y en última instancia llegan también a los humanos. Y el efecto de ese plástico ingerido sobre la salud es algo que todavía se está intentado averiguar.
El químico de la Universidad de La Laguna explica que el plástico es una macromolécula con unos enlaces muy estables, por lo que generalmente no es posible que se degrade al ingerirla. El problema es que al plástico se le añaden aditivos para darle ciertas propiedades: plastificantes para facilitar su moldeado, colorantes, endurecedores o fotoprotectores. Esos aditivos, al no formar parte de la matriz polimérica del plástico, es muy fácil que se liberen en algún momento, facilitando que puedan terminar ingeridos. “Sus efectos es algo que todavía se está estudiando. Se ha visto que en algunos peces produce un cierto estrés oxidativo y en otros afecta al crecimiento, pero son datos que la comunidad científica está todavía analizando”.
Pero es que, además de esos aditivos, los microplásticos, sobre todo en el medio marino, son capaces de retener contaminantes persistentes, como los bifenilos policlorados (que están prohibidos), herbicidas organoclorados (la mayoría también prohibida) e hidrocarburos aromáticos policíclicos, entre otros. Y, de nuevo, cabe preguntar qué ocurre al ingerir microplásticos que tienen en su superficie esos contaminantes. “Parece ser que esa liberación no es tan grande, pero son estudios muy preliminares y se han hecho con los contaminantes persistentes, pero no con los emergentes, que son compuestos que se sospecha que pueden ser contaminantes, como por ejemplo fármacos, productos de higiene personal como los filtros UV de las cremas solares, drogas de abuso… una serie de compuestos relativamente recientes que se está sospechando que pueden ser perjudiciales para el medio ambiente y las personas”.
La situación en la Macaronesia
Prácticamente al año de su fundación, el grupo de investigación en Química Analítica Aplicada logró 1.340.000 euros de financiación europea para poner en marcha un proyecto de la convocatoria Interreg-MAC 2014-2020 denominado IMPLAMAC, que fue presentado en noviembre de 2019 y su objetivo principal es estudiar el impacto de los microplásticos y contaminantes emergentes en las costas de la Macaronesia. Está liderado por la Universidad de La Laguna y participan también la Universidad de Las Palmas de Gran Canaria; la Agencia Nacional para el Desarrollo de la Investigación, la Tecnología y la Innovación de Madeira; la Secretaría Regional de Ambiente y Recursos Naturales de Madeira; la Dirección Regional de Asuntos del Mar de Azores y la Universidad de Cabo Verde.
Lograr este proyecto fue el espaldarazo definitivo para poner en marcha la actividad del grupo de investigación, que en sus inicios tenía solamente tres personas y, en gran medida gracias a este proyecto europeo, del cual el equipo de la Universidad de La Laguna gestiona directamente unos 600.000 euros, ya cuenta con nueve personas.
IMPLAMAC analizará microplásticos hallados en playas y en alta mar de toda la Macaronesia, incluyendo también muestras de arena y agua para buscar contaminantes, sobre todo emergentes, y definir en dónde se localizan y en qué cantidades.
Si recoger las muestras es ya una tarea ardua porque exige desplazamientos y travesías en alta mar para realizar el muestreo, el análisis posterior de las muestras es igualmente complejo: los microplásticos entre 5 y 1 milímetros son visibles al ojo humano y se pueden ver relativamente bien. “Ese tipo de análisis es más sencillo, aunque arduo”, explica Hernández Borges. “Hay que tamizar la muestra, lo tamizado se somete a flotación en una disolución saturada de cloruro sódico para aumentar la densidad del agua y que los microplásticos floten. Se hace una inspección visual de cada microplástico y hay que contarlos, ver sus colores, su forma una a una y pesarlos, y todo ello a mano, porque, de momento, no es un proceso automatizado”.
Afortunadamente, la Universidad de Las Palmas de Gran Canaria ha desarrollado un software que permite hacer un recuento a partir de una fotografía y esta tecnología va a ser utilizada en IMPLAMAC. Además de este análisis visual con lupa binocular, se utilizarán técnicas de espectroscopia infrarroja y tipo Raman para confirmar su composición.
IMPLAMAC, al ser un proyecto Interreg, conlleva una importante carga de difusión. Al contrario que en otros tipos de convocatorias donde los resultados se presentan al final, el formato de este programa exige estar realizando una comunicación continua de resultados, con un evento de lanzamiento, otro de cierre y algunos otros entre medias, sin contar los artículos en revistas científicas e, incluso, la organización de cursos, charlas y seminarios: “estuvimos en la Universidad de Verano de Adeje y en la de Verano de La Gomera, ahora tenemos cursos de Extensión en Arico y puede que en La Guancha, y un curso transdisciplinar 100% on-line donde vamos a abordar la perspectiva de los microplásticos en tierra, mar y aire con expertos que estado muestreado desde avión a 3.000 metros, otros en el Ártico, la Antártida, en aguas residuales… algo muy completo”.
Un factor del que se muestra especialmente orgulloso Hernández Borges en referencia a IMPLAMAC es que ha propiciado un movimiento de participación ciudadana que, en su opinión, revaloriza el proyecto de manera importante: en Tenerife colaboran con el proyecto Ciencia Ciudadana promovido por el Cabildo Insular, consistente en que el ciudadano de a pie puede “apadrinar” una playa y ayudar a los investigadores a realizar los muestreos tras ser previamente formado para ello. Se cuenta con la Asociación Terramare para encontrar los voluntarios y se ha extendido a todas las islas de la provincia: en La Palma se colabora a través de la Asociación Oceanológico y en La Gomera y El Hierrro, con Ventana al Mar.
“Esta participación ciudadana y voluntaria, en todos los años que llevo investigando no la había visto nunca. El problema ha calado porque se lo hemos explicado con rigurosidad. Porque a veces estos problemas se tratan con sensacionalismo y yo creo que así lo que logramos es, justamente, alejar a muchas personas. A la gente le gusta que la universidad salga a la calle como ella sabe: con rigor, aportando datos científicos recientes y contrastados”.
Las playas de Canarias
Además de este proyecto europeo, el grupo de investigación en Química Analítica Aplicada se ha visto recientemente envuelto en otro proyecto igualmente ambicioso, esta vez circunscrito al ámbito canario, que cuenta con el apoyo de la Fundación Diario de Avisos y que fue presentado a finales de septiembre de 2020. De alguna manera, viene a complementar a IMPLAMAC, puesto que si este se centra en la fracción más grande de microplásticos, de entre 5 y 1 milímetros, el de la fundación lo hace en aquellos de tamaño inferior, y centrados únicamente en los fondos arenosos de las playas de las ochos islas canarias.
En este proyecto se lleva trabajando desde julio de 2020, tomando muestras en cuatro playas de cada isla -con la excepción de La Graciosa, en la que solamente se muestreará una zona del litoral- para determinar los microplásticos que hay en profundidad. La investigación se desarrollará durante un año y será igualmente dura porque, además de los exhaustivos análisis de laboratorio ya explicados, se añade la dificultad de que las muestras se obtienen del fondo marino y, por tanto, es necesario realizar inmersiones.
La idea es realizar un diagnóstico de la situación en Canarias, habida cuenta de que la llegada de microplásticos y otros residuos a las costas del archipiélago es especialmente abundante por las corrientes que afectan a sus costas. Gracias a este diagnóstico se espera poder detectar “puntos negros” y, así, articular medidas preventivas o, al menos, intensificar las campañas de limpieza. Por ahora, según Hernández Borges, ya se han detectado tres de estos focos en Playa Grande de Arico, Famara en Lanzarote y Playa Lambra (o Playa del Ámbar) en La Graciosa y, a falta de confirmar los datos obtenidos, es muy probable que Arenas Blancas en El Hierro podría ser otro.
En el análisis de fondos se está observado la gran presencia de plásticos en forma de microfibras provenientes de tejidos, liberados al mar a través de los lavados de la ropa. Las depuradoras más modernas pueden eliminar en torno al 95 % de estos residuos, pero las más antiguas, de las cuales siguen muchas en activo, llegan en torno a un 80 % de filtrado. “Y otro problema es que lo eliminado se queda en los lodos, y si con ellos se abonan los campos, pues se están liberando en tierra”.
Por desgracia, no todos los plásticos se pueden reciclar: los hay que se derriten al aplicar altas temperaturas y pueden ser así reutilizados para otros fines. Pero existen plásticos termoestables, como los empleados para fabricar utensilios de cocina, que no se pueden volver a moldear ni reciclar. “Y al medio ambiente llegan ambos tipos. Se están buscando soluciones, estamos colaborando con una empresa que está investigando qué hacer con la materia prima que recogemos. Se la suministramos tal cual nos llega y ellos ven si se puede utilizar como combustible o qué tratamiento habría que hacer”.
En todo caso, la línea de investigación sobre microplásticos en la Universidad de La Laguna está en pleno auge. Como muestra, Hernández Borges pone énfasis en que, hasta el momento, ya se han hecho seis trabajos fin de grado y uno fin de máster sobre la materia, y además ya están en marcha tres tesis doctorales. Además, se está ampliado la investigación hacia otros campos, como la búsqueda de estos residuos en organismos vivos como lubinas y doradas y, próximamente, también en erizos de mar. “Así, colaboramos con biólogos marinos, edafólogos, físicos que nos están ayudando en los análisis, obviamente con químicos… Es un equipo multidisciplinar y cada vez nos llaman más a la puerta para colaborar. Nuestra idea es consolidar esta línea de investigación y abrirla todavía más”.
Gabinete de Comunicación